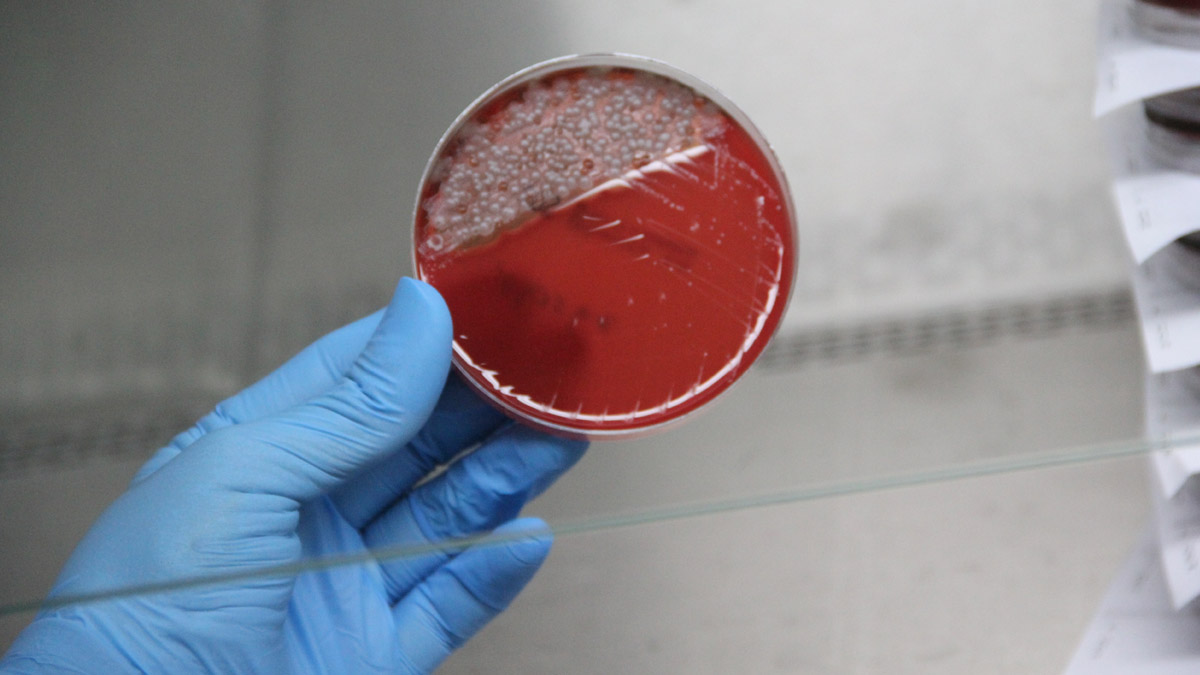
Mikrop saçıyorlar! İşte 1 haftalık maskedeki bakteriler

İlk olarak Aralık 2019'da Çin'in Vuhan kentinde ortaya çıkan ve tüm dünyayı saran yeni tip koronavirüs (Kovid-19) salgını sürecinde maske kullanımın ne kadar önemli olduğu bütün bilim camiası tarafından kabul edildi. Doğru kullanıldığı takdirde virüsten koruyan maskeler uzun süre kullanılması halinde tehlike saçıyor.
İŞTE 1 HAFTALIK MASKEDEKİ BAKTERİLER
Ondokuz Mayıs Üniversitesi (OMÜ) Mikrobiyoloji Anabilim Dalında görevli akademisyenler tarafından yapılan testte, 1 hafta kullanılan maske üzerinde bulunan bakteriler gözler önüne serildi.

HANGİ TİP MASKE DAHA GÜVENİLİR, NEDEN?
Uzun süre kullanılan maskelerin ne kadar temiz olduğuna dair bilgi veren OMÜ Mikrobiyoloji Anabilim Dalında görevli Doç. Dr. Yeliz Tanrıverdi Çaycı, "Maalesef halk arasında maskelerin 1 gün, 1 hafta ve daha uzun süre kullanıldığını duyuyoruz" diyerek sözlerine şöyle devam etti:
"Cerrahi maskelerin özellikle nemlendiği, öksürüldüğü ve hapşırıldığı zaman kesinlikle tekrar kullanılmamasını istiyoruz. 1 haftayı bırakın aynı gün içerisinde bile hapşırılma, öksürme ve nemlendiğini hissediyorsak mutlaka maskelerimizi değiştirilmeliyiz. Aksi takdirde orada çeşitli bakteriler ve mikroorganizmalar üreyebiliyor. Bizim de yaptığımız testte görüldüğü gibi 1 haftalık maskenin üzerinde birçok bakteri üreyebiliyor ve kullananın sağlığına da zarar veriyor. Ayrıca maskenin etkinliğini de azaltmaktadır. Bu nedenle maskelerin tekrar tekrar günlerce kullanılmasını kesinlikle tavsiye etmiyoruz."

'YIKANIP ASLA TEKRAR TEKRAR KULLANILMAMALI'
Bez maske yerine tıbbi maske kullanılmasını tavsiye eden Doç. Dr. Çaycı, “Kişiler eğer kalabalık bir ortama giriyorlar ise cerrahi maske takmalarını öneriyoruz. Maskeleri yüzlerine tam yerleştirmelerini ve orta kısmına kesinlikle elleri ile dokunmamaları gerekiyor. Çıkartırken de lastik kısımlarından tutarak çıkarmalıdır ve uygun şekilde atmalarını öneriyoruz. Tıbbi maskeler yıkanıp tekrar tekrar kesinlikle kullanılmamalıdır. Bez maskeler kullanılabilir ancak kullanıldıktan sonra yüksek ısıda yıkanıp ütülenmeleri gerekmektedir. Özellikle kalabalık bir ortama girilecekse eğer bez maskeden ziyade tıbbı maske kullanılmasını öneriyoruz” diye konuştu.
Talebin yoğun olmasının ardından, simitçi, saatçi, giyim mağazası, çantası, telefoncu, seyyar tezgah ve bijuteri dükkanlarında bile maske satılmaya başlandı. Tıbbi bir ürün olan maskelerin satışı ise ya 5’li paketlerde ya 50’li paketlerde ya da tekli bir şekilde yapılıyor. Uzmanlar ise vatandaşları özellikle 'merdiven altı' olarak tabir edilen yöntemle izinsiz üretilen maskelere karşı, ağzı kapatan her ürünün maske olmadığına dikkat çekerek uyarıyor. Sağlık Bakanlığı Bilim Kurulu Üyesi Doç. Dr. Afşin Emre Kayıpmaz ise bez maskelerin 5 defadan fazla kullanılmaması gerektiğini söylemişti.